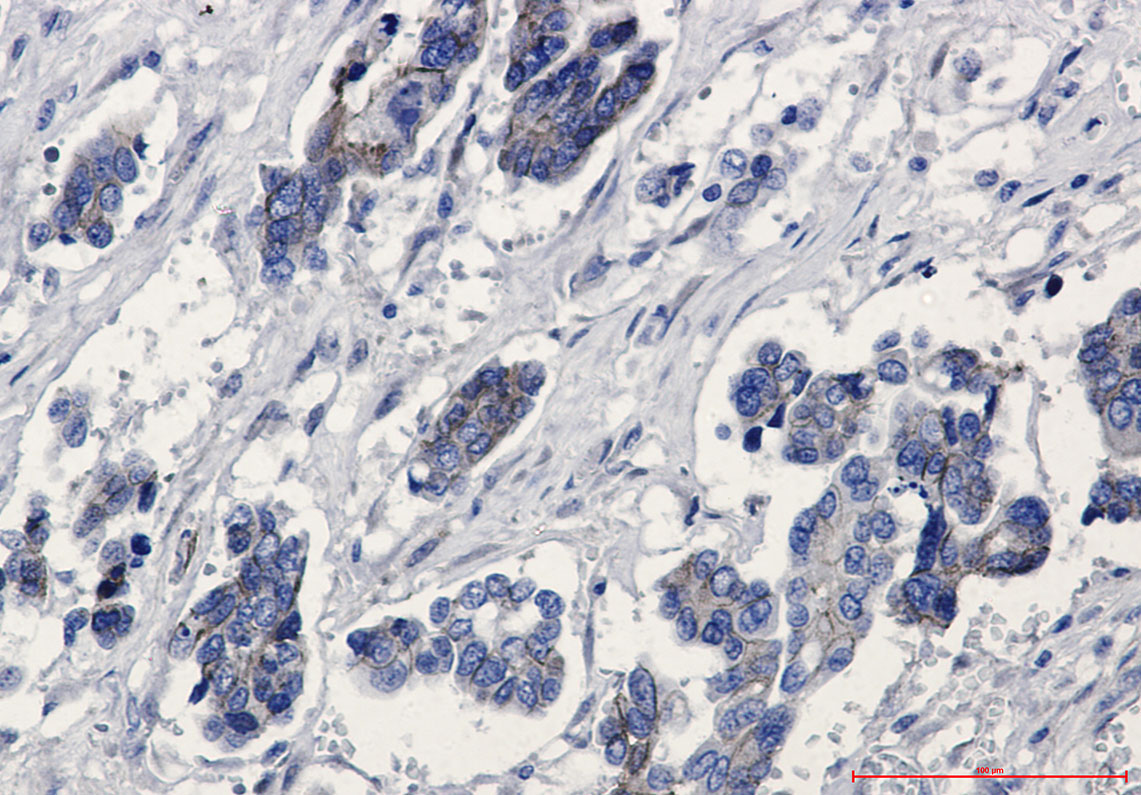
Rabbit Monoclonal Antibody to beta Catenin

提醒成功

搜索
Rabbit Monoclonal Antibody to beta Catenin
-
货号:
P22680 -
别名:
CTNNB1; CTNNB; OK/SW-cl.35; Catenin beta-1; Beta-catenin -
应用:
WB,IP,IHC -
反应种属:
Human,Mouse,Rat,Hamster -
抗体类型:
Primary antibody -
Swissprot:
P35222 -
规格:
-
数量:
-+ -
说明书:
目录价¥2180

Rabbit Monoclonal Antibody to beta Catenin
Description |
|---|
Beta-catenin is an adherens junction protein. Adherens junctions (AJs; also called the zonula adherens) are critical for the establishment and maintenance of epithelial layers, such as those lining organ surfaces. AJs mediate adhesion between cells, communicate a signal that neighboring cells are present, and anchor the actin cytoskeleton. In serving these roles, AJs regulate normal cell growth and behavior. |
Specification |
|
|---|---|
| Aliases | CTNNB1; CTNNB; OK/SW-cl.35; Catenin beta-1; Beta-catenin |
| Entrez GeneID | 1499 |
| Swissprot | P35222 |
| WB Predicted band size | Calculated MW: 85 kDa; Observed MW: 85 kDa |
| Host/Isotype | Rabbit IgG |
| Antibody Type | Primary antibody |
| Storage | Store at 4°C short term. Aliquot and store at -20°C long term. Avoid freeze/thaw cycles. |
| Species Reactivity | Human,Mouse,Rat,Hamster |
| Immunogen | A synthetic peptide of human beta Catenin |
| Formulation | Purified antibody in TBS with 0.05% sodium azide,0.05%BSA and 50% glycerol. |
Application |
|
|---|---|
| WB | 1/500-1/1000 |
| IP | 1/10-1/20 |
| IHC | 1/50-1/100 |
Product Image
- Western blot analysis of beta Catenin in mouse brain lysates using beta Catenin antibody.
- Western blot analysis of beta Catenin in C6, CHO-K1, Hela lysates using beta Catenin antibody.
- Immunohistochemistry analysis of paraffin-embedded Human Cholangiocarcinoma using beta Catenin antibody. High-pressure and temperature Sodium Citrate pH 6.0 was used for antigen retrieval.
For Reseach Only
Application Key:WB - Western Blot | IHC - Immunohistochemistry | ICC - Immunocytochemistry | FCM - Flow Cytometry | ELISA - Enzyme-linked Immunosorbent Assay | IP - Immunoprecipitation
#P22680

相关产品















 微信/QQ登录
微信/QQ登录


 首页
首页